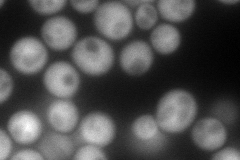
YML004C
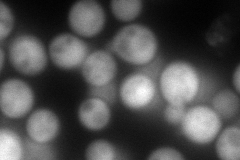
YML004C
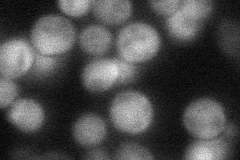
YML004C

View description
Monomeric glyoxalase I, catalyzes the detoxification of methylglyoxal (a by-product of glycolysis) via condensation with glutathione to produce S-D-lactoylglutathione; expression regulated by methylglyoxal levels and osmotic stress
Localization:
Intensity:
Fold change:
Significance:
-
C’ GFP library in SD

cytosol23.15 -
N' NOP1pr-GFP in SD
cytosol202.064 -
N' TEF2pr-mCherry in SD
cytosol217.601 -
N' NATIVEpr-GFP in SD
cytosol44.403 -
N' TEF2pr-VC and Cyto-VN in SD

cytosol47.0161 -
C’ GFP library in SD+DTT

cytosol51.382.21Yes -
C’ GFP library in SD+H2O2

cytosol30.421.31No -
C’ GFP library in Starvation Media

cytosol64.382.78Yes -
C’ GFP library on the background of Pup2-DaMP

cytosol -
C’ GFP library on the background of CCT mutant

cytosol25.95161.12077No
